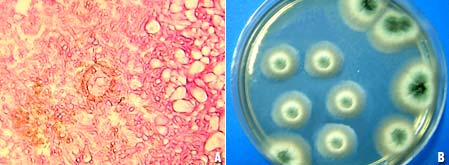

|
|
Nesta seção estaremos apresentando periodicamente casos clínicos e artigos da área de micologia médica. › Ocorrência de Aspergillus sp em pacientes com sinusite crônica |
Ocorrência de Aspergillus
sp em pacientes com sinusite crônica A Sinusite, inflamação da mucosa dos
seios paranasais, pode ser decorrente de alterações
anatômicas, processos infecciosos, alérgicos ou da
carga fúngica ambiental. Materiais e métodos Estudo de 4 casos de pacientes com sinusite crônica: • Caso 1 - Pct. Masc., 42 anos, portador de Desvio de Septo Nasal (DSN) com antecedentes de Rinite Alérgica (RA). Após rinoplastia e septostomia eliminou pelas fossas nasais, secreção amarronzada e espessa, que foi processada em meios de Ágar Sabouraud-cloranfenicol e Ágar sangue para análise microbiológica. • Caso 2 - Pct. Masc., 50 anos, portador de linfoma com queixas de obstrução nasal. Foram recolhidos fragmentos teciduais pardo-amarelados por cirurgia endoscópica para exames histopatológico e cultura micológica em Ágar Sabouraud-cloranfenicol. • Caso 3 - Pct. Fem., 42 anos, portadora de DSN, RA e sinusites de repetição. Durante septoplastia e sinusectomia foi recolhido de seio maxilar, material de aspecto friável para a realização de pesquisa micológica, em KOH a 30%, e exame histopatológico. • Caso 4 - Pct. Fem., 69 anos, com antecedentes de sinusite crônica. Após procedimento invasivo craniano desenvolveu processo inflamatório com cefaléia e sinais obstrutivos. Realizada punção da base do crânio, com retirada de secreção purulenta, procedeu-se à cultura micológica em Ágar Sabouraud-cloranfenicol. Resultados • Caso 1 – O cultivo em Ágar Sabouraud-cloranfenicol demonstrou crescimento de colônias de Aspergillus sp (Figura 1).
• Caso 2 - O exame histopatológico, em coloração de Hematoxilina-eosina evidenciou hifas septadas e cabeças aspergilares; a cultura micológica em Ágar Sabouraud-cloranfenicol desenvolveu colônias de Aspergillus sp (Figura 2).
• Caso 3 - O exame micológico direto e o exame histopatológico corado pela Hematoxilina-eosina indicaram a presença de hifas septadas, grosseiras, algumas mostrando dicotomia com filamentos em ângulo agudo (Figura 3). A cultura micológica não foi realizada, pois a amostra encontrava-se fixada em formol.
• Caso 4- Em Ágar Sabouraud-cloranfenicol houve crescimento de colônias brancas no início, depois cinza-esverdeadas, veludosas que após microcultivo foi identificado como Aspergillus fumigatus (Figura 4).
Conclusão É de suma importância
a investigação fúngica em sinusite crônica
principalmente maxilar, unilateral, com rinorréia espessa
e escura sem resposta à terapia antibacteriana; evitando
desta forma, complicações decorrentes dessa patologia,
como o abscesso cerebral e a meningite. |
||
| O site micologia.com.br é uma idealização da Dra. Rossana Sette de Melo Rêgo, médica, especialista em micologia (UFPE). |